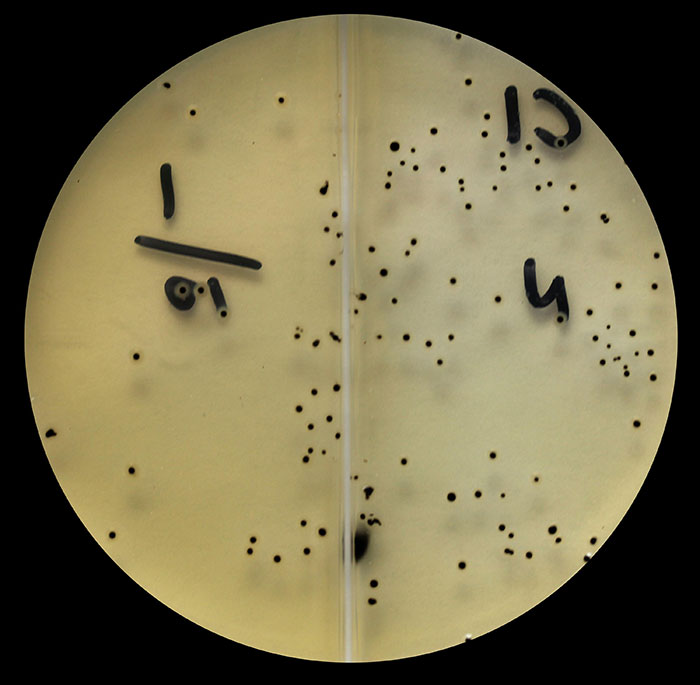
Figure 2

- Infectious Diseases of Livestock
- Part 3
- Clostridium perfringens group infections
- GENERAL INTRODUCTION: SPIROCHAETES
- Swine dysentery
- Borrelia theileri infection
- Borrelia suilla infection
- Lyme disease in livestock
- Leptospirosis
- GENERAL INTRODUCTION: AEROBIC ⁄ MICRO-AEROPHILIC, MOTILE, HELICAL ⁄ VIBROID GRAM-NEGATIVE BACTERIA
- Genital campylobacteriosis in cattle
- Proliferative enteropathies of pigs
- Campylobacter jejuni infection
- GENERAL INTRODUCTION: GRAM-NEGATIVE AEROBIC OR CAPNOPHILIC RODS AND COCCI
- Moraxella spp. infections
- Bordetella bronchiseptica infections
- Pseudomonas spp. infections
- Glanders
- Melioidosis
- Brucella spp. infections
- Bovine brucellosis
- Brucella ovis infection
- Brucella melitensis infection
- Brucella suis infection
- Brucella infections in terrestrial wildlife
- GENERAL INTRODUCTION: FACULTATIVELY ANAEROBIC GRAM NEGATIVE RODS
- Klebsiella spp. infections
- Escherichia coli infections
- Salmonella spp. infections
- Bovine salmonellosis
- Ovine and caprine salmonellosis
- Porcine salmonellosis
- Equine salmonellosis
- Yersinia spp. infections
- Haemophilus and Histophilus spp. infections
- Haemophilus parasuis infection
- Histophilus somni disease complex in cattle
- Actinobacillus spp. infections
- infections
- Actinobacillus equuli infections
- Gram-negative pleomorphic infections: Actinobacillus seminis, Histophilus ovis and Histophilus somni
- Porcine pleuropneumonia
- Actinobacillus suis infections
- Pasteurella and Mannheimia spp. infections
- Pneumonic mannheimiosis and pasteurellosis of cattle
- Haemorrhagic septicaemia
- Pasteurellosis in sheep and goats
- Porcine pasteurellosis
- Progressive atrophic rhinitis
- GENERAL INTRODUCTION: ANAEROBIC GRAM-NEGATIVE, IRREGULAR RODS
- Fusobacterium necrophorum, Dichelobacter (Bacteroides) nodosus and Bacteroides spp. infections
- GENERAL INTRODUCTION: GRAM-POSITIVE COCCI
- Staphylococcus spp. infections
- Staphylococcus aureus infections
- Exudative epidermitis
- Other Staphylococcus spp. infections
- Streptococcus spp. infections
- Strangles
- Streptococcus suis infections
- Streptococcus porcinus infections
- Other Streptococcus spp. infections
- GENERAL INTRODUCTION: ENDOSPORE-FORMING GRAM-POSITIVE RODS AND COCCI
- Anthrax
- Clostridium perfringens group infections
- Clostridium perfringens type A infections
- Clostridium perfringens type B infections
- Clostridium perfringens type C infections
- Clostridium perfringens type D infections
- Malignant oedema⁄gas gangrene group of Clostridium spp.
- Clostridium chauvoei infections
- Clostridium novyi infections
- Clostridium septicum infections
- Other clostridial infections
- Tetanus
- Botulism
- GENERAL INTRODUCTION: REGULAR, NON-SPORING, GRAM-POSITIVE RODS
- Listeriosis
- Erysipelothrix rhusiopathiae infections
- GENERAL INTRODUCTION: IRREGULAR, NON-SPORING, GRAM-POSITIVE RODS
- Corynebacterium pseudotuberculosis infections
- Corynebacterium renale group infections
- Bolo disease
- Actinomyces bovis infections
- Trueperella pyogenes infections
- Actinobaculum suis infections
- Actinomyces hyovaginalis infections
- GENERAL INTRODUCTION: MYCOBACTERIA
- Tuberculosis
- Paratuberculosis
- GENERAL INTRODUCTION: ACTINOMYCETES
- Nocardiosis
- Rhodococcus equi infections
- Dermatophilosis
- GENERAL INTRODUCTION: MOLLICUTES
- Contagious bovine pleuropneumonia
- Contagious caprine pleuropneumonia
- Mycoplasmal pneumonia of pigs
- Mycoplasmal polyserositis and arthritis of pigs
- Mycoplasmal arthritis of pigs
- Bovine genital mycoplasmosis
- Neurotoxin-producing group of Clostridium spp.
- Contagious equine metritis
- Tyzzer's disease
- MYCOTIC AND ALGAL DISEASES: Mycoses
- MYCOTIC AND ALGAL DISEASES: Pneumocystosis
- MYCOTIC AND ALGAL DISEASES: Protothecosis and other algal diseases
- DISEASE COMPLEXES / UNKNOWN AETIOLOGY: Epivag
- DISEASE COMPLEXES / UNKNOWN AETIOLOGY: Ulcerative balanoposthitis and vulvovaginitis of sheep
- DISEASE COMPLEXES / UNKNOWN AETIOLOGY: Ill thrift
- Eperythrozoonosis
- Bovine haemobartonellosis
Clostridium perfringens group infections
This content is distributed under the following licence: Attribution-NonCommercial CC BY-NC
View Creative Commons Licence details here
Clostridium perfringens group infections
Current authors:
F A UZAL - Professor and Branch Chief, DVM, FRVC, MSc, PhD, Dipl. ACVP, California Animal Health and Food Safety Lab, University of California, Davis, San Bernardino, California, 92408, USA.
M NAVARRO - Assistant Professor of Veterinary Anatomic Pathology, DVM, MSc, PhD, Dipl. ACVP, Universidad Austral de Chile, Campus Isla Teja, Valdivia, Chile.
N P J KRIEK - Emeritus Professor, BVSc, MMed Vet (Path), Onderstepoort, Pretoria, Gauteng, 0110, South Africa.
P HUNTER-OBEREM - Self Employed, BVSc Hons, Mont Lorraine, Gauteng, South Africa.
General introduction
Clostridium perfringens, previously referred to as Clostridium welchii, was first described in 1891 by Achalme as the Bacillus of Acute Articular Rheumatism.103 In the historical literature it was also known by names such as Bacillus phlegmonis emphysematosae, Bacillus emphysematis vaginae, Bacillus cadaveris butyricus, Bacillus aerogenes capsulatus, Granulobacillus saccharobutyricus liquefaciens immobilis, and as Bacillus perfringens.103, 106
Clostridium perfringens is a typical representative of the genus Clostridium, which requires anaerobic growth conditions. It is widely distributed in nature and occurs in soil, sewage and water, as well as in the intestinal tract of humans and warm- and some cold-blooded animals. Clostridium perfringens is usually absent from the stomach, but present in variable numbers (vegetative bacteria and spores) in the small and large intestines of most animals. Vegetative organisms may multiply in soil105 and counts as high as 5 × 104 C. perfringens organisms per gram of soil have been recorded.105, 111 Normal human intestinal contents can contain as many as 109 organisms per gram,1 the number being dependent on the diet of the host.2 In pigs fed on a high protein diet, the number of C. perfringens is significantly higher than in pigs on a standard protein diet.50 Higher faecal counts of C. perfringens are found in calves aged between one and ten days than in older animals.4
The different Clostridium perfringens types produce six major toxins: alpha (CPA), beta (CPB), epsilon (ETX), iota (ITX), enterotoxin (CPE), and necrotic enteritis B-like (NetB), which are used for typing them into toxin types A, B, C, D, E, F and G (Table 1).77 Each one of these types also produces a number of so-called minor, less lethal toxins. Under certain in vivo and in vitro conditions the major and minor toxins are produced alone or in combination, depending on the specific type, and are responsible for the pathogenicity of the bacterium.77, 116, 117 These toxins, alone or in combination, are responsible for the various syndromes associated with this group of organisms. They cause disease as a consequence of their local effects on the intestinal tract, which may vary from insignificant to outspoken, and/or the systemic effect of absorbed toxins — a situation referred to as enterotoxaemia.
The effects of these toxins, also referred to as virulence factors, are divided into three groups, namely:104
- the alpha and kappa toxins, which are phospholipase C (lecithinase) and collagenase enzymes, respectively, hydrolyze substances essential to the integrity of cellular membranes or other body structures;
- a group that includes the beta, epsilon, iota, enterotoxin and NetB toxins, that are pore forming toxins
- a group that includes the haemolytic toxins such as the theta and delta toxins.
Clostridium perfringens is associated with a wide variety of diseases (Table 2) that affect most domestic animal species and humans and include enterotoxaemia, haemorrhagic and necrotic enteritis, and gas gangrene.53, 62, 64, 106, 110, 122 It is one of the most widespread and potential pathogenic organisms in nature. C. perfringens type F, producing enterotoxin is an important cause of food poisoning in humans.53, 102, 103
Clostridium perfringens grows well on rabbit, human, ovine, bovine and equine blood agar at 35 to 37 °C in an anaerobic atmosphere. After 18 to 24 hours’ incubation, the colonies are 2 to 5mm in diameter, white or grey and translucent, with a glossy appearance, low convex, and round with edges that may vary from irregular/serrated in some isolates to entire in most isolates. Pure cultures of C. perfringens frequently contain two or more colony forms, with aberrant forms sometimes occurring alongside the typical colony forms. On ovine, bovine, rabbit, and human blood agar, colonies are surrounded by a narrow zone of complete haemolysis caused by the theta toxin, surrounded by a wider zone of partial haemolysis caused by the alpha toxin (Figure 1). On horse blood agar, only the theta toxin is responsible for haemolysis. The alpha toxin has relatively little effect on horse and goat red blood cells.53, 80, 103 Clostridium perfringens tolerates a wide temperature range when incubated and, although the optimal range is 35 to 37 °C, temperatures of 43 to 45 °C, are tolerated. When grown under optimal conditions the generation time (i.e. the time it takes an organism to double itself) of C. perfringens may be as short as eight minutes, which makes it probably the most rapidly growing organism known.106
Different media have been composed for the selective isolation of C. perfringens in the presence of other organisms. The addition of antibiotics, such as neomycin, to the tryptonesulphite- neomycin medium of Marshall, Steenbergen and McClung,51 allows selective growth of the C. perfringens organism whilst suppressing the growth of contaminants. The OPSP medium of Handford and Cavett29 and Handford28 contains oleandomycin, polymyxin and sulphadiazine that suppress the growth of Clostridium bifermentans, a common contaminant, more effectively than the tryptose-sulphitecycloserine medium of Harmon, Kautter and Peeler.31 Another selective medium containing lactose and metabisulphite has been found to be more effective than tryptose-sulphite-cycloserine agar.68 The addition of 0,1 per cent sodium metabisulphite to an agar medium containing C. perfringens results in the formation of black colonies due to the presence of ferrous sulphide, which is formed by the reduction of sulphite to sulphide by C. perfringens in the medium (Figure 2).104 This facilitates the selection of C. perfringens for preparing pure subcultures on the same or other media. Currently, several selective media for culturing C. perfringens are commercially available.
Clostridium perfringens grows in a variety of liquid media. Of these, Robertson’s cooked-meat medium is probably the best known, since it has been extensively and successfully used for culturing the clostridia for many years.22, 49, 110 The compilation of a fluid medium for the production of one of the exotoxins of C. perfringens is common practice, and one that is frequently used comprises a peptone base, such as proteose peptone, to which salts and carbohydrates are added.36, 56, 66 A synthetic medium, which facilitates the purification of toxin produced in it, consists of purified amino acids, vitamins, purine and pyrimidine bases, salts, carbohydrates and reducing agents.58, 59 Synthetic media require more time to prepare and are usually much more expensive to produce. They are used more for research than for routine diagnostic purposes.
For routine diagnostic purposes, fluid media (such as thioglycolate broth, cooked-meat broth and brain-heart infusion broth) are commonly used. These are commercially available, easy to prepare and relatively inexpensive, and are used as the primary inoculation of different carbohydrate media to determine their fermentation reactions and the toxin-producing ability of each strain.53
Clostridium perfringens exist in the faeces of animals in different physiological states. It may occur in vegetative cell forms, in sporulating cell forms, as endospores, or as germinating endospores. The physiological states that the bacterium may be in, require different methods of isolation to recover it successfully. The methods used include direct culture, pre-enrichment in cooked meat, pre-heating with or without ethanol, and pre-treatment with heat before pre-enrichment.53, 67
Clostridium perfringens is a Gram-positive, short, squat, thick, straight-sided, non-motile bacillus, measuring 0,6–0,8 x 1,2–4 μm (Figure 3). Very short forms occur under conditions that facilitate rapid growth of the organism. The bacteria usually occur singly or in pairs, and rarely in chains.9, 122
In animal tissues, but only in certain media, the organisms form a capsule that is demonstrated by negative staining with India ink. The capsule is composed of complex polysaccharides combined with peptides of acidic amino acids.106
Although the members of the genus Clostridium are characterized as being a spore-forming group of organisms, spores of C. perfringens are rarely seen on standard artificial media or in animal tissues. Media have been compiled that encourage the organisms to produce spores under artificial laboratory conditions; yields of up to 106–7 spores per millilitre have been recorded.80. It appears that there is considerable variation from one strain to another in the conditions required for sporulation.57 Spores are oval and located sub-terminally. Sporulation is usually associated with the formation of enterotoxin,45 which in humans causes a form of food poisoning characterized by abdominal pain, diarrhoea and nausea.32, 118 The spores are heat-resistant, but here too there is considerable variation between different strains, some surviving exposure to 100 °C for one to five hours, while others do not. The majority of spores from heat-resistant strains require heat activation (75 to 100 °C for ten minutes or more) to germinate.45, 106
A variety of carbohydrates and other substances metabolized by C. perfringens are used in the identification and classification of isolates of the organism. For practical purposes the biochemical reactions should be the same for all C. perfringens types. Ninety per cent of C. perfringens strains ferment fructose, galactose, glucose, inositol, lactose, maltose, mannose, starch, and sucrose; liquefy gelatine; produce toxin, and are pathogenic for laboratory animals. Eleven to 89 per cent of strains ferment cellobiose, glycerol, glycogen, inulin, raffinose, ribose, salicin, and trehalose, hydrolyse casein, and reduce nitrates and acetylmethyl carbinol while only about 1 per cent produce urease. Ninety per cent of C. perfringens strains do not ferment adonitol, amygdalin, arabinose, cellulose, dulcitol, erythritol, esculin, mannitol, melezitose, melibiose, rhamnose, sorbitol, sorbose, trehalose, or xylose.108 The fermentation products formed include acetic and butyric acids, with or without butanol. These reactions play an important role in confirming the identity of C. perfringens but have no bearing on the toxin type. Once biochemically characterized, toxin typing is performed by PCR.77 Because all C. perfringens strains encode the cpa gene, PCR for this gene is currently also used to determine the species.77
The use of polymerase chain reaction (PCR) technology has led to much improved in vitro test methods for typing. These tests are not only faster to perform, but are also more reliable and specific, and are rapidly becoming the method of choice with which to identify and type strains of C. perfringens.38, 77
Typing of the various strains by PCR is dependent on the amplification of the cpa, cpb, etx, itx, cpe and netB genes from the relevant C. perfringens strains.77 The PCR technique can be used to type bacteria in field samples collected from animal tissues, as well as those which have been propagated on solid or in fluid media.38
Major and minor toxins produced Clostridium perfringens, and their effects
Alpha toxin (CPA)
All C. perfringens isolates encode CPA. The cpa gene is located in a stable region of the chromosome.113 The alpha toxin was the first bacterial toxin ever to have its biochemical mode of action elucidated. It is a protein, an enzyme, slightly heat-stable and antigenic, and can be toxoided. The alpha toxin is a phospholipase C enzyme specifically defined as phosphatidylcholine cholinephosphohydrolase, and has marked preference for phospholipids including sphingomyelin, phosphatidylcholine (lecithin), phosphatidylethanolamine, phosphatidylserine and glycerophosphatides. It catalyzes the hydrolysis of the phosphodiester bond in position three of the lecithin molecule to produce phosphorylcholine and water-insoluble 1,2- diacylglyceride.
CPA consists of a membrane-binding C-domain composed of a β-sheet, a catalytic N-domain composed of α-helices, and a central loop domain containing a ganglioside (GM1a) binding site.71 Based on its antigenic properties and/or amino acid sequences, CPA is related to the phospholipases produced by Clostridium bifermentans, Clostridium novyi, Clostridium absonum and Clostridium barati.74 The alpha toxin has a molecular weight ranging between 49 000 and 53 000 Daltons and an isoelectric point of 5,4.55, 107 CPA is produced by C. perfringens type A in both continuous and batch cultures containing pre-reduced media, with optimal production occurring at a pH of 7,0 and at 37 °C.72 This toxin is a comparatively thermostable enzyme that can retain 45 per cent of its activity when heated for 10 to 15 minutes at 100 °C. As zinc stabilizes the phospholipase C in the presence of proteases, it is believed that this enzyme is a zinc metalloenzyme.101 Zinc ions confer a certain resistance to the haemolysis of sheep erythrocytes by phospholipase C, probably by stabilizing their membranes. The enzyme activity is dependent on the presence of calcium, which acts on the substrate rather than on the enzyme itself. Divalent cations and positively charged detergents activate phospholipase C by inducing a positive charge on the substrate, which optimizes the attachment of the negatively charged enzyme. Under normal in vitro conditions, phospholipase C is inhibited by phosphate, citrate, fluoride and substances that bind calcium.101
The main biological features of CPA are its ability to cause localized necrosis of skin when sublethal doses are injected intradermally in guinea pigs or rabbits, its lethality to laboratory animals, such as mice, guinea pigs and rabbits when administered parenterally, and its in vitro ability to cause haemolysis of erythrocytes of certain animals.23, 24 These three activities of CPA were regarded as inseparable, but each may be expressed separately by chemically modifying the purified toxin.83
CPA exhibits its phospholipase C action by producing an opalescent reaction, the outcome of which is visible as a white precipitate in agar media containing lecithin, egg yolk or human serum. This enzyme reaction was initially and individually observed in 1939 by Nagler and Seifert, and is referred to as the ‘Nagler’ reaction.63 This reaction is used to assay CPA activity in culture supernatant fluid and during purification procedures of the toxin.55, 81 The hydrolysis of p-nitrophenylphoshorylcholine also facilitates the detection of alpha toxin enzyme activity.47
Erythrocytes of cattle and mice are the most susceptible to the haemolytic activity of CPA, those of rabbits, sheep and humans are moderately so, while horse erythrocytes are relatively insensitive.34 Erythrocytes of some animal species, such as sheep, exhibit a ‘hot-cold’ lysis phenomenon; the erythrocytes do not lyse when exposed to the toxin at 37 °C but do when they are cooled down to 4°C.106 Apart from its effect on erythrocytes, CPA also lyses blood platelets and leukocytes, stimulates the in vivo and in vitro release of histamine from mast cells, and damages the cell membranes of fibroblasts and muscle cells. In one study it was found that purified alpha toxin alone does not alter the viability, chemotactic responsiveness or morphology of human polymorphonuclear leukocytes. It does evoke leukocytolytic activity, but only in the presence of theta toxin or perfringolysin.110 The formation of thrombi in venules, capillaries and arterioles is an important early event in the pathogenesis of necrosis caused by the alpha toxin.52 The intravenous administration of alpha toxin results in the aggregation and lysis of platelets, a preliminary reduction followed by an increase in the blood clotting time, the formation of abnormally soft and friable clots, massive intravascular haemolysis, and damage to capillary endothelial cells with a resultant increase in their permeability.104, 106 CPA is a vigorous inhibitor of the calcium pump of cardiac sarcoplasmic reticulum (Ca++Mg++ ATP-ase) that may lead to the depletion of releasable Ca++ in myocytes,75 which in turn causes a reduction of systolic myocardial function and a decrease in contractility. If this decrease in myocardial function is significant, a substantial decrease in cardiac output may be responsible for the induction of shock which occurs in C. perfringens histotoxic infections. These in vivo lethal and shock effects of alpha toxin and the direct myocardial-depressant effect seen in vitro, are well documented.121 Experimentally, following a single intravenous injection, alpha toxin disappears from the blood stream within 10 to 20 minutes, the liver being responsible for 72 per cent of its uptake from the blood. Several molecular pathways and cellular responses associated with CPA have recently been reviewed in detail.65
Beta toxin (CPB)
The cpb gene that encodes CPB is carried on large virulence plasmids of both type B and C isolates,25, 94 CPB is produced as a 336 amino acid pro-toxin that contains a 27-amino acid signal sequence, which is cleaved during secretion, resulting in toxin maturation to. the ~35 kDa active toxin.81 CPB has an isoelectric point of 5, 6.123 It is heat-labile, loses 75 per cent of its biological activity after 5 minutes at 50 °C, and is destroyed by trypsin after 30 minutes at 37 °C.82, 83
CPB is a beta pore-form toxin (β-PFT), which belongs to the α-haemolysin family. This toxin has some amino acid sequence similarity with the β-PFTs of Staphylococcus aureus.33 The receptor for CPB toxin has not been definitely identified. While previous studies suggested that P2X7 is the receptor for CPB on THP-1 cells,61 platelet endothelial cell adhesion molecule-1 (CD31 or ECAM-1) has recently been shown to be a CPB receptor on endothelial cells.7
CPB acts on the cytoplasmic membrane of susceptible cells by forming functional pores that allow the influx of Ca2+, Na+ and Cl- into the cytoplasm, and produce cell swelling.61 These pores also allow efflux of potassium that induces phosphorylation of p38 MAP and JNK kinases, both of which can activate host cell adaptation and survival pathways.60 CPB is exquisitely sensitive to intestinal proteases, including trypsin,119 and different CPB variants have variable trypsin sensitivity and in vitro cytotoxic effects in vitro.112
Purified beta toxin has a minimum lethal dose of 4 μg in mice, and after intradermal injection, 2 μg elicits a dermonecrotic effect. The maximum lethal dose of beta toxin required to kill an animal is 400 ng/kg body weight.21 Following administration in ligated intestinal loops in vivo in guinea pigs and rabbits, it causes haemorrhage and necrosis of the intestinal mucosa.37, 95
Epsilon toxin (ETX)
The etx gene encoding ETX, is carried on plasmids in type B and D isolates.93 ETX is structurally similar to the aerolysin toxin produced by Aeromonas sp., and, because of that, ETX is classified as a heptameric β-PFT of the aerolysin family.73 The characteristic double β-barrel of this toxin family, is thought to be important for pore formation.92 Although the myelin and lymphocyte (MAL) protein is currently considered a strong ETX-receptor candidate79 the presence of this protein has not yet been demonstrated in cells of C. perfringens type B or D natural hosts.
ETX has a molecular mass in the region of 23 200 to 25 000 Daltons and a toxicity of 3,0–4,2 x 106 MLD/mg protein.26, 27 The prototoxin is produced during the logarithmic phase of growth, apparently within the cell, from which it diffuses into the surrounding medium. This prototoxin has been demonstrated in the vegetative cell and spores of type D isolates.
ETX is released in the form of a ~33kDa prototoxin. Full activation occurs when trypsin, α-chymotrypsin, carboxypeptidases and possibly other intestinal proteases remove the 13 N-terminal and 29 C-terminal residues of the protoxin. The mature toxin is a 1000 times more toxic than the prototoxin.15, 54
The isoelectric point for the major peak of prototoxin is 8,02, while activated ETX has two major peaks with pI values of 5,36 and 5,74, respectively. This significant change in the isoelectric point and the small change in molecular mass that occurs after the activation of the prototoxin, has led to the suggestion that activation results in removal of a small and highly basic peptide from the molecule. The activation also results in some conformational change. It would seem that there is a tendency of the cleavage product to bind to the remaining active toxin molecule, which gives the toxin a conformational and serological identity similar to that of the prototoxin. Under certain conditions, however, this rebinding of the cleavage product can be prevented. It is not clear whether or not the conformational change resulting from activation is a necessary prerequisite for toxicity.5
ETX is not haemolytic, but it is locally necrotizing when injected intradermally into guinea pigs and rabbits, and highly lethal when administered parenterally to laboratory animals such as mice, rabbits, guinea pigs and lambs.17, 23, 24, 110
Numerous descriptions of the biological effects of the epsilon toxin have been reported. It causes increased vascular permeability, which is independent of the release of histamine, in the intestine and central nervous system,10, 18, 19, 20, 23, 24 and in the skin of guinea pigs. In rats, ETX has a pressor effect on the blood pressure, which is increased without there being changes in electrocardiographic recordings or heart rate. This is accompanied by a decrease in cutaneous blood flow, suggesting that the toxin exerts a vasoconstrictor effect.91
Contraction of rats’ ileum is induced by the epsilon toxin due to the activation of Na+ channels, releasing acetylcholine from cholinergic nerve endings, which in turn promotes the availability of Ca++, causing contraction of the smooth muscle.98 Loss of its lethal activity can be achieved by the addition of ethoxyformic anhydride to solutions containing the toxin. This has led to the suggestion that a single histidine residue on the surface of the toxin is responsible for its lethal activity.85, 86, 87 It has also been reported that one tryptophan residue84, 85, 86, 87 one tyrosine residue,89 several lysine residues, 85, 86, 87 and several carboxyl groups are necessary to maintain the lethal activity of the ETX.90
Guinea pig peritoneal macrophages are readily killed in vitro by ETX, but guinea pig lymphocytes and pulmonary alveolar macrophages remain viable after similar treatment.14 peritoneal macrophages, although also susceptible to the action of the epsilon toxin, are less so than the guinea pig cells. Rabbit lymphocytes and pulmonary alveolar macrophages possess the same measure of resistance to the toxin14 as those of guinea pigs. No demonstrable in vitro effect has been noted in other cell types from guinea pigs, rabbits, mice and sheep.64
Iota toxin
Iota toxin (ITX), produced by C. perfringens type E is a binary toxin that consists of two components: an enzyme (Ia) and a binding component (Ib).88 The genes iap and ibp, which encode both components, are located on large, conjugative plasmids.44 ITX is similar to ETX in that it has to be activated by proteolytic enzymes such as trypsin or proteinase, to its toxic form. ITX has a molecular mass of 45 000 Daltons and is heat labile (it is inactivated after 15 minutes at 53 to 60 °C).
The lipolysis-stimulated lipoprotein (LSR, also known as angulin-1) is the receptor for Ib.96 After binding to its receptor on target cells, the Ib binding component oligomerizes into heptamers that insert into the plasma membrane, forming functional channels, thus facilitating the movement of ions and the translocation and endocytosis of the enzymatic component Ia (enzymatic component).65 Once endocytosed, Ia translocates itself into the cytoplasm where it induces depolymerization of actin filaments and an increase of G-actin monomers.114 When injected intradermally in guinea-pigs, it is dermonecrotic, and after intravenous injection, it is lethal. Clostridium perfringens type E has only very rarely been isolated from diseased animals.51
Clostridium perfringens enterotoxin (CPE)
CPE is a 35kDa single polypeptide, which is produced by all type F strains, and more rarely, by some type C, D and E strains. This toxin belongs to the aerolysin beta pore-forming toxin family6, 41 and it consists of an N-terminal cytotoxicity domain that mediates oligomerization and membrane insertion during pore formation, and a C-terminal receptor binding domain.16 The cell receptors of CPE are several claudins39, 99 including claudins-3 and -4 with which CPE binds with high affinity, claudins-8 and -14 (moderate affinity binding), and claudins-1 and -2 (poor affinity binding or no affinity at all).100
After binding to a claudin receptor, CPE becomes part of an ~90kDa-small complex in which there is also a claudin receptor and a non-receptor claudin-1.76 Then approximately 6 small complexes oligomerize and form a ∼450kDa pre-pore on the plasma membrane surface.76 A beta-hairpin loop extends from each CPE molecule in the pre-pore, and assembles into a beta-barrel, which inserts into the membrane to create a 1.4 nm pore.13 Experimental treatment with low CPE doses causes a limited Ca++ influx that induces mild calpain activation that triggers caspase 3-mediated apoptosis.11 However, higher CPE doses cause a much larger Ca++ influx, which induces a strong calpain activation leading to MLKL-dependent necroptosis.11 RIP1 and RIP3 are also involved in both CPE-induced apoptosis and necroptosis99, 100
Necrotic enteritis B-like (NetB)
NetB is a 33kDa single-chain protein.40 This toxin is a member of the a-haemolysin family of b-PFTs and it shares homology with several other pore-forming toxins, including a 31 per cent similarity with CPB.40 As with other members of the a-haemolysin PFT family, the NetB monomer has four domains: the β-sandwich, latch, rim and pre-stem domains.124
The NetB receptor remains unidentified. This toxin forms heptameric pores on susceptible cell membranes and the b-barrel channel of this pore has a strong preference for cations.124
Other Clostridium perfringens toxins.
Beta2 toxin (CPB2)
CPB2 is a 28kDa pore-forming toxin, which was first identified in a C. perfringens isolate obtained from a piglet suffering from necrotic enteritis.20 Since then, the gene (cpb2) encoding this toxin has been detected in isolates from a wide variety of animals such as cattle, sheep and goats, horses, chicken and swine and humans with and without enteric disease.120
The involvement of CPB2 in intestinal diseases of animals remains unproven and controversial. The mode of action and receptor for CPB2 are also unclear.
Delta toxin
The delta toxin is a 32kDa single-chain protein, produced by some of the type B and C strains, and it is encoded by a gene (cpd) that is located on yet uncharacterized plasmids. Delta toxin belongs to the a-haemolysin branch of the beta-pore b-PFT family and has homology with CPB (43 per cent identity), NetB (39.6 per cent identity), NetF (39 per centidentity), and alpha-toxin of S. aureus (32 per cent identity).3, 48
The receptor for delta toxin has not yet been determined, but Ganglioside GM2 has been suggested as a potential candidate.48 The role of delta toxin on the pathogenesis of C. perfringens types B and C disease has not been determined, although it generates ~4 nm pores on biological membranes,48 and causes fluid accumulation and intestinal damage in mice intestinal loops.97
Perfringolysin O (PFO) or theta toxin
Perfringolysin O is produced by all except type F C. perfringens strains with the chromosomal cpe gene or type C Darmbrand strains.116 PFO, a pore-forming toxin, is the prototype of cholesterol-dependent cytolysins.73 The mature protein is ~53 kDa and consists of 472 amino acids.115 PFO has high affinity for its cholesterol receptor on the membranes of target cells.78
The large pores formed by PFO in the plasma membrane of target cells produce lysis by an osmotic mechanism30 being its main activity.73 PFO acts synergistically with CPA to cause myonecrosis12 by contributing to tissue destruction, and preventing bacterial lysis by host immune cells.73 At high concentrations, PFO is cytotoxic for macrophages and polymorphonuclear leukocytes, and at lower concentrations, this toxin impairs superoxide anion production, respiratory burst and phagocytosis of complement-opsonized particles.8, 109 This toxin also prevents actin filament polymerization in leukocytes and, therefore, migration of neutrophils,8, 109 and allows the escape of C. perfringens from phagosomes by contributing to the lysis of the endosome membrane in macrophages.69, 70
Degradative C. perfringens enzymes
The sialidases (neuraminidases) are the best-studied C. perfringens degradative enzymes. These enzymes generate free sialic acids from various sialoglycoconjugates found on host cell surfaces or in mucus.46 Three sialidases, NanJ, NanI and NanH, are produced by C. perfringens.
The kappa toxin, with a molecular mass of approximately 80 000 Daltons, is a protein free of carbohydrate, heat-labile (enzyme activity is destroyed by heating to 60 °C for 10 minutes), and sensitive to low pH (the activity is destroyed at pH 4,5 or below). It has been purified by gel filtration and ion exchange chromatography.42, 52, 103, 106 It has collagenase and gelatinase activities, by catalysing the non-polar region of the collagen molecule. This enzyme is primarily produced by C. perfringens types A, D and E, and possibly also by types B and C.
The kappa toxin is lethal when injected intravenously into mice and causes necrosis when injected intracutaneously into rabbits. Parenteral administration of the toxin to guinea pigs results in extensive destruction of connective tissue and severe pulmonary haemorrhage.
It has been suggested that it plays a role in the development of gas gangrene (myonecrosis) by softening the infected muscle tissue, thus facilitating the spread of the alpha toxin,52, 103, 106 and promoting the invasiveness of the causative pathogen.109
The mu toxin is a hyaluronidase produced by most strains of types A and B, some strains of type D and a few strains of type C.103, 106 It acts by releasing glucosamine from hyaluronic acid and, like most other proteins, it is heat-labile, being destroyed at temperatures above 50 °C, and remains active at pH levels varying from 3,9 to 8,5. The toxin has haemolytic, necrotic and lethal activities, and causes an increase in skin permeability.103
The role played by the mu toxin in the pathogenesis of disease is unknown, as there is no definite proof for the existence of a relationship between the production of the toxin and the virulence of the organism. It has, however, been suggested that, while it does not seem to be essential for the development of gas gangrene, it may well contribute to the severity or rapidity of the development and expansion of the lesions.52
The nu toxin is a deoxyribonuclease that is produced by all strains of C. perfringens except by certain type C strains isolated from humans. It is secreted into the culture medium in which it is growing during its logarithmic growth phase, is very thermolabile, and is inhibited by the divalent copper and zinc metal ions, and by citrate.35 It is assumed that the nu toxin exhibits lethal and haemolytic activities, and it has been demonstrated that it has specific cytotoxic activities in that it destroys the nuclei of polymorphonuclear leukocytes and muscle cells in gas gangrene – the absence of these leukocytes in lesions of gas gangrene bears testimony to this.52, 106
Specimens that should be collected for the diagnosis of the C. perfringens group of diseases
Confirmation of a diagnosis of disease caused by C. perfringens depends on the toxinotype involved. For enteric infections in general, detection of the toxins in intestinal content and/or faeces is required. Isolation followed by PCR typing of the C. perfringens isolate is helpful in some, but not in all cases. Some types of C. perfringens (e.g. type A) are present in the intestine of most animals and isolation of this toxinotype has, therefore, no diagnostic significance. For histotoxic infections, isolation or demonstration of C. perfringens by PCR, fluorescent antibody test and/or immunohistochemistry, is diagnostic. Specimens should be collected as soon as possible after the death of the animal. The specimens collected and investigation performed will vary according to the specific disease and are discussed in the relevant chapters.
Drug sensitivity of C. perfringens
Most strains of C. perfringens are susceptible to metronidazole, penicillin G, erythromycin, chloramphenicol and amoxycillin with clavulanic acid. Antibiotics such as tetracycline and clindamycin are not always effective against these anaerobes. Clostridium perfringens is completely resistant to the aminoglycosides, which include neomycin, streptomycin, gentamycin and kanamycin, and most of the cephalosporins.80 Strains isolated from pig faeces are resistant to tetracycline, erythromycin, lincomycin and clindamycin, a situation possibly associated with the extensive use of these antibiotics in animal feeds. Clostridium perfringens isolated from the intestinal contents of calves is susceptible to chloramphenicol, chlortetracycline, erythromycin, penicillin G, ampicillin, nitrofurantoin, furazolidone and trimethoprim, and resistant to neomycin, streptomycin, kanamycin, gentamycin and polymyxin.4 In strains isolated from poultry, ampicillin, penicillin G, rifampicin, salinomycin and tylosin appear to be the most effective antibiotics.43 Antimicrobial agents, such as the aminoglycosides, bacitracin, monensin, nalidixic acid and the tetracyclines, are much less effective.
Table 2. Main diseases produced by Clostridium perfringens53
| Toxinotype | Diseases and species affected |
|---|---|
| A | Gas gangrene of humans and several animals; possible involvement in haemorrhagic gastroenteritis in dogs and horses |
| B | Lamb dysentery |
| C | Haemorrhagic and necrotizing enteritis of several neonatal animals; enteritis necroticans (pig-bel, Darmbrand) in humans |
| D | Enterotoxaemia in sheep, goats and cattle |
| E | Possible involvement in gastroenteritis of cattle and rabbits |
| F | Human food poisoning, antibiotic associated diarrhoea and sporadic diarrhoea |
| G | Necrotic enteritis of poultry |
Legend to Figures
Figure 1: Colonies of C. perfringens on blood agar surrounded by a narrow zone of complete haemolysis caused by the perfringolysin, around which is a wider zone of partial haemolysis caused by the alpha toxin.
Figure 2: Black colonies of C. perfringens on selective sodium metabisulphite agar, which allows the identification of C. perfringens.
Figure 3: Smear of the small intestinal mucosa of a sheep with enterotoxaemia showing large numbers of Gram-positive C. perfringens. The organisms are short, squat, thick, and straight-sided.
References
- AKAMA, K. &OTANI, S., 1970. Clostridium perfringens as the flora in the intestine of healthy persons. Japanese Journal of Medical Science and Biology, 23, 161-175.
- ALLISON, M. J., ROBINSON, I. M., DOUGHERTY, R. W. &BUCKLIN, J. A., 1975. Grain overload in cattle and sheep: changes in microbial populations in the cecum and rumen. American Journal of Veterinary Research, 36(2), 181-185.
- ALOUF, J. E. &JOLIVET-REYNAUD, C., 1981. Purification and characterization of Clostridium perfringens delta-toxin. Infection and Immunity, 31(2), 536-546.
- AMTSBERG, G., BISPING, W., KRABISCH, P. &MATTHIESEN, I., 1977. Zum Vorkommen und zur pathogenen Bedeutung von Clostridium perfringens beim Kalb 1: 1. Mitteilung: Quantitative bakteriologische Untersuchungen zum Clostridium perringens‐Keimgehalt im Kot und Darminhalt von gesunden und erkrankten Kälbern. Zentralblatt für Veterinärmedizin Reihe B, 24(2), 104-113
- BHOWN, A. S. &HABEEB, A. F., 1977. Structural studies on epsilon prototoxin of Clostridium perfringens type D localization of the site of tryptic scission necessary for activation to epsilon toxin. Biochemical and Biophysical Research Communications, 78, 889-896.
- BRIGGS, D. C., NAYLOR, C. E., SMEDLEY III, J. G., LUKOYANOVA, N., ROBERTSON, S., MOSS, D. S., MCCLANE, B. A. &BASAK, A. K., 2011. Structure of the food-poisoning Clostridium perfringens enterotoxin reveals similarity to the aerolysin-like pore-forming toxins. Journal of Molecular Biology, 413(1), 138-149.
- BRUGGISSER, J., TAREK, B., WYDER, M., MÜLLER, P., VON BALLMOOS, C., WITZ, G., ENZMANN, G., DEUTSCH, U., ENGELHARDT, B. &POSTHAUS, H., 2020. CD31 (PECAM-1) serves as the endothelial cell-specific receptor of Clostridium perfringens β-toxin. Cell Host & Microbe, 28(1), 69-78.
- BRYANT, A. E., BERGSTROM, R., ZIMMERMAN, G. A., SALYER, J. L., HILL, H. R., TWETEN, R. K., SATO, H. &STEVENS, D. L., 1993. Clostridium perfringens invasiveness is enhanced by effects of theta toxin upon PMNL structure and function: the roles of leukocytotoxicity and expression of CD11/CD18 adherence glycoprotein. FEMS Immunology and Medical Microbiology, 7(4), 21-336.
- BULLEN, J. J. &BATTY, I., 1957. Experimental enterotoxaemia of sheep: The effect on the permeability of the intestine and the stimulation of antitoxin production in immune animals. Journal of Pathology and Bacteriology, 73, 511-518
- BUXTON, D., 1978. Further studies on the mode of action of Clostridium welchii type D epsilon toxin. Journal of Medical Microbiology, 11, 293-298.
- CHAKRABARTI, G., ZHOU, X. &MCCLANE, B. A., 2003. Death pathways activated in CaCo-2 cells by Clostridium perfringens enterotoxin. Infection and Immunity, 71(8), 4260-4270.
- CHAKRAVORTY, A., AWAD, M. M., HISCOX, T. J., CHEUNG, J. K., CARTER, G. P., CHOO, J. M., LYRAS, D. &ROOD, J. I., 2011. The cysteine protease α-clostripain is not essential for the pathogenesis of Clostridium perfringens-mediated myonecrosis. PLoS One, 6(7), e22762.
- CHEN, J., THEORET, J. R., SHRESTHA, A., SMEDLEY III, J. G. &MCCLANE, B. A., 2012. Cysteine-scanning mutagenesis supports the importance of Clostridium perfringens enterotoxin amino acids 80 to 106 for membrane insertion and pore formation. Infection and Immunity, 80(12), 4078-4088.
- DAUBE, G., SIMON, P., LIMBOURG, B., MANTECA, C., MAINIL, J. &KAECKENBEECK, A., 1996. Hybridization of 2,659 Clostridium perfringens isolates with gene probes for seven toxins (alpha, beta, epsilon, iota, theta, mu, and enterotoxin) and for sialidase. American Journal of Veterinary Research, 57(4), 496-501.
- FREEDMAN, J. C., LI, J., UZAL, F. A. &MCCLANE, B. A., 2014. Proteolytic processing and activation of Clostridium perfringens epsilon toxin by caprine small intestinal contents. MBio, 5(5), e01994-14
- FREEDMAN, J. C., SHRESTHA, A. &MCCLANE, B. A., 2016. Clostridium perfringens enterotoxin: action, genetics, and translational applications. Toxins, 8(3), 73.
- GARCIA, J. P., ADAMS, V., BEINGESSER, J., HUGHES, M. L., POON, R., LYRAS, D., HILL, A., MCCLANE, B. A., ROOD, J. I. &UZAL, F. A., 2013. Epsilon toxin is essential for the virulence of Clostridium perfringens type D infection in sheep, goats, and mice. Infection and Immunity, 81(7), 2405-2414.
- GARDNER, D. E., 1973a. Pathology of Clostridium welchii type D enterotoxaemia. I. Biochemical and haematological alterations in lambs. Journal of Comparative Pathology, 83, 509-524.
- GARDNER, D. E., 1973b. Pathology of Clostridium welchii type D enterotoxaemia. II. Structural and ultrastructural alterations in the tissues of lambs and mice. Journal of Comparative Pathology, 83, 499-507.
- GILBERT, S. A., TIMONEY, P. J., MCCOLLUM, W. H. &DEREGT, D., 1997. Detection of equine arteritis virus in the semen of carrier stallions by using a sensitive nested PCR assay. Journal of Clinical Microbiology, 35, 2181– 2183.
- GLENNY, A. T., BARR, M., LLEWELLYN-JONES, M., DALLING, T. &ROSS, H. E., 1933. Multiple toxins produced by some organisms of the Cl. welchii Group. Journal of Pathology and Bacteriology, 37, 53-74.
- GOLDNER, S. B., SOLBERG, M., JONES, S. &POST, L. S., 1986. Enterotoxin synthesis by nonsporulating cultures of Clostridium perfringens. Applied and Environmental Microbiology, 52(3), 407-412.
- GRINER, L. A., 1961. Enterotoxaemia of sheep. I. Effects of Clostridium perfringens type D on the brains of sheep and mice. American Journal of Veterinary Research, 22, 429-442.
- GRINER, L. A. &CARLSON, W. D., 1961. Enterotoxaemia of sheep. II. Distribution of I131 radio iodinated serum albumin in brains of Clostridium perfringens type D intoxicated lambs. American Journal of Veterinary Research, 22, 443-446.
- GURJAR, A., LI, J. &MCCLANE, B. A., 2010. Characterization of toxin plasmids in Clostridium perfringens type C isolates. Infection and immunity, 78(11), 4860-4869.
- HABEEB, A. F., 1969. Studies on E prototoxin of Clostridium perfringens type D. I. Purification methods: Evidence for multiple forms of E prototoxin. Archives in Biochemistry and Biophysics, 130, 430-440.
- HANDFORD, P. M., 1974. A new medium for the detection and enumeration of Clostridium perfringens in foods. Journal of Applied Bacteriology, 37, 559-570.
- HANDFORD, P. M. &CAVETT, J. J., 1973. Medium for detection and enumeration of Clostridium-perfringens (welchii) in foods. Journal of the Science of Food and Agriculture, 24, 487-487.
- HARMON, S. M., 1984. Clostridium perfringens: Enumeration and identification. In: Bacteriological Analytical Manual of the Division of Microbiology Centre for Food Safety and Applied Nutrition, U.S. Food and Drug Administration. 6th edition, Virginia: Association of Official Analytical Chemists.
- HARRIS, R. W., SIMS, P. J. &TWETEN, R. K., 1991. Evidence that Clostridium perfringens theta-toxin induces colloid-osmotic lysis of erythrocytes. Infection and Immunity, 59(7), 2499-2501.
- HAUSCHILD, A. H. W., 1971. Clostridium perfringens toxins types B, C, D and E. In: KADIS, S., MONTIE, T.C. & AJL, S. J., (eds.). Microbial Toxins, IIA, New York and London: Academic Press.
- HAUSCHILD, A. H. W., NIILO, L. &DORWARD, W. J., 1970. Enteropathogenic factors of food-poisoning Clostridium perfringens type A. Canadian Journal of Microbiology, 16(5), 331-338.
- HUNTER, S. E., BROWN, J. E., OYSTON, P. C., SAKURAI, J. &TITBALL, R. W., 1993. Molecular genetic analysis of beta-toxin of Clostridium perfringens reveals sequence homology with alpha-toxin, gamma-toxin, and leukocidin of Staphylococcus aureus. Infection and Immunity, 61(9), 3958-3965.
- ISPOLATOVSKAYA, M. V., 1971. Type A Clostridium perfringens toxin. In: KADIS, S., MONTIE, T. C. & AJL, S. J. (eds.). Microbial Toxins, IIA, New York and London: Academic Press.
- JAYKO, L. G. &LICHSTEIN, H. C., 1959. Nutritional factors concerned with growth and lecithinase production by C. perfringens. Journal of Infectious Diseases, 104, 142-151.
- JOLIVET-REYNAUD, C., POPOFF, M. R. &VINIT, M., 1986. Enteropathogenicity of Clostridium perfringens beta toxin and other clostridial toxins. Zentralblatt für Bakteriologie, Mikrobiologie und Hygiene, Suppl, 15, 145-151.
- KADRA, B., GUILLOU, J. P., POPOFF, M. &BOURLIOUX, P., 1999. Typing of sheep clinical isolates and identification of enterotoxigenic Clostridium perfringens strains by classical methods and by polymerase chain reaction (PCR). FEMS Immunology and Medical Microbiology, 24(3), 259-266.
- KAMEYAMA, S. &AKAMA, K., 1971. Purification and some properties of kappa toxin of Clostridium perfringens. Japanese Journal of Medical Science and Biology, 24, 9-23.
- KATAHIRA, J., SUGIYAMA, H., INOUE, N., HORIGUCHI, Y., MATSUDA, M. &SUGIMOTO, N., 1997. Clostridium perfringens enterotoxin utilizes two structurally related membrane proteins as functional receptors in vivo. Journal of Biological Chemistry, 272(42), 26652-26658.
- KEYBURN, A. L., BOYCE, J. D., VAZ, P., BANNAM, T. L., FORD, M. E., PARKER, D., DI RUBBO, A., ROOD, J. I. &MOORE, R. J., 2008. NetB, a new toxin that is associated with avian necrotic enteritis caused by Clostridium perfringens. PLoS Pathogens, 4(2), e26.
- KITADOKORO, K., NISHIMURA, K., KAMITANI, S., FUKUI-MIYAZAKI, A., TOSHIMA, H., ABE, H., KAMATA, Y., SUGITA-KONISHI, Y., YAMAMOTO, S., KARATANI, H. &HORIGUCHI, Y., 2011. Crystal structure of Clostridium perfringens enterotoxin displays features of β-pore-forming toxins. Journal of Biological Chemistry, 286(22), 19549-19555.
- KLAASEN, H. L., MOLKENBOER, M. J., BAKKER, J., MISEREZ, R., HÄNI, H., FREY, J., POPOFF, M. R. &VAN DEN BOSCH, J. F., 1999. Detection of the β2 toxin gene of Clostridium perfringens in diarrhoeic piglets in The Netherlands and Switzerland. FEMS Immunology and Medical Microbiology, 24(3), 325-332.
- KONDO, F., 1988. In vitro lecithinase activity and sensitivity to 22 antimicrobial agents of Clostridium perfringens isolated from necrotic enteritis of broiler chickens. Research in Veterinary Science, 45, 337-340.
- LI, J., MIYAMOTO, K. &MCCLANE, B. A., 2007. Comparison of virulence plasmids among Clostridium perfringens type E isolates. Infection and Immunity, 75(4), 1811-1819.
- LI, J., PAREDES-SABJA, D., SARKER, M. R. &MCCLANE, B. A., 2016. Clostridium perfringens sporulation and sporulation-associated toxin production. Microbiology spectrum, 4(3), 4-3.
- LI, J., UZAL, F. A. &MCCLANE, B. A., 2016. Clostridium perfringens sialidases: potential contributors to intestinal pathogenesis and therapeutic targets. Toxins, 8(11), 341.
- MACFARLANE, M. G. &KNIGHT, B. C. J. C., 1941. The biochemistry of bacterial toxins. The lecithinase activity of Clostridium welchii. Biochemical Journal, 35, 884-901.
- MANICH, M., KNAPP, O., GIBERT, M., MAIER, E., JOLIVET-REYNAUD, C., GENY, B., BENZ, R. &POPOFF, M. R., 2008. Clostridium perfringens delta toxin is sequence related to beta toxin, NetB, and Staphylococcus pore-forming toxins, but shows functional differences. PLoS One, 3(11), e3764.
- MÅNSSON, I., NORBERG, R., OLHAGEN, B. &BJÖRKLUND, N. E., 1971. Arthritis in pigs induced by dietary factors. Microbiologic, clinical and histologic studies. Clinical and Experimental Immunology, 9(5), 677.
- MARSHALL, R. S., STEENBERGEN, J. F. &MCCLUNG, L. S., 1965. Rapid technique for the enumeration of Clostridium perfringens. Applied Microbiology, 13(4), 559-563.
- MCDONEL, J. L., 1986. Clostridium perfringens toxins (type A, B, C, D, E). Pharmacology and Therapy, 10, 617-655.
- MEER, R. R. &SONGER, J. G., 1997. Multiplex polymerase chain reaction assay for genotyping Clostridium perfringens. American Journal of Veterinary Research, 58, 702-705.
- MEHDIZADEH GOHARI, I. A., NAVARRO, M., LI, J., SHRESTHA, A., UZAL, F. &MCCLANE, B. A., 2021. Pathogenicity and virulence of Clostridium perfringens. Virulence, 12(1), 723-753.
- MINAMI, J., KATAYAMA, S., MATSUSHITA, O., MATSUSHITA, C. &OKABE, A., 1997. Lambda-toxin of Clostridium perfringens activates the precursor of epsilon-toxin by releasing its N-and C-terminal peptides. Microbiology and Immunology, 41(7), 527-535.
- MÖLLBY, R., HOLME, T., NORD, C. E., SMYTH, C. J. &WADSTRÖM, T., 1976. Production of phospholipase C (alpha-toxin), haemolysins and lethal toxins by Clostridium perfringens types A to D. Microbiology, 96(1), 137-144.
- MUHAMMED, S. I., MORRISON, S. M. &BOYD, W. L., 1975. Nutritional requirements for growth and sporulation of Clostridium perfringens. Journal of Applied Bacteriology, 38(3), 245-253.
- MURATA, R. &YAMAMOTO, A., 1964. A synthetic medium for production of alpha toxin by C. perfringens. Japanese Journal of Medical Science and Biology, 17, 211-213.
- MURATA, R., YAMAMOTO, A., SODA, S. &ITO, A., 1965. Nutritional requirements of Clostridium perfringens PB6K for alpha toxin production. Japanese Journal of Medical Science and Biology, 18(4), 189-202.
- MYRVIK, Q. N. &WEISER, R. S., 1988. Fundamentals of Medical Bacteriology and Mycology, Philadelphia: Lea & Febiger.
- NAGAHAMA, M., HAYASHI, S., MORIMITSU, S. &SAKURAI, J., 2003. Biological activities and pore formation of Clostridium perfringens beta toxin in HL 60 cells. Journal of Biological Chemistry, 278(38), 36934-36941.
- NAGAHAMA, M., SEIKE, S., SHIRAI, H., TAKAGISHI, T., KOBAYASHI, K., TAKEHARA, M. &SAKURAI, J., 2015. Role of P2X7 receptor in Clostridium perfringens beta-toxin-mediated cellular injury. Biochimica et Biophysica Acta (BBA)-General Subjects, 1850(11), 2159-2167.
- NAGLER, F. P. O., 1940. Observations on a reaction between lethal toxins of Cl. welchii (Type A) and human serum. British Journal of Experimental Pathology, 20, 473-485.
- NAKAMURA, M. I. T. S. U. R. U., COOK, J. A. &CROSS, W. R., 1968. Lecithinase production by Clostridium perfringens in chemically defined media. Applied Microbiology, 16(9), 1420-1421.
- NAVARRO, M. A., LI, J., BEINGESSER, J., MCCLANE, B. A. &UZAL, F. A., 2020. The Agr-like quorum-sensing system is important for Clostridium perfringens type A strain ATCC 3624 to cause gas gangrene in a mouse model. Msphere, 5(3), pp.e00500-20.
- NAVARRO, M. A., MCCLANE, B. A. &UZAL, F. A., 2018. Mechanisms of action and cell death associated with Clostridium perfringens toxins. Toxins, 10(5), 212.
- NETHERWOOD, T., CHANTER, N. &MUMFORD, J. A., 1996. Improved isolation of Clostridium perfringens from foal faeces. Research in Veterinary Science, 61(2), 147-151.
- NEUT, C., PATHAK, J., ROMOND, C. &BEERENS, H., 1985. Rapid detection of Clostridium perfringens: comparison of lactose sulfite broth with tryptose-sulfite-cycloserine agar. Journal of the Association of Official Analytical Chemists, 68(5), 881-883.
- NIILO, L., 1971. Mechanism of action of the enteropathogenic factor of Clostridium perfringens type A. Infection and Immunity, 3, 100-106.
- O’BRIEN, D. K. &MELVILLE, S. B., 2004. Effects of Clostridium perfringens alpha-toxin (PLC) and perfringolysin O (PFO) on cytotoxicity to macrophages, on escape from the phagosomes of macrophages, and on persistence of C. perfringens in host tissues. Infection and Immunity, 72(9), 5204-5215.
- O’BRIEN, D. K. &MELVILLLE, S. B., 2000. The anaerobic pathogen Clostridium perfringens can escape the phagosome of macrophages under aerobic conditions. Cellular Microbiology, 2(6), 505-519.
- ODA, M., TERAO, Y., SAKURAI, J. &NAGAHAMA, M., 2015. Membrane-binding mechanism of Clostridium perfringens alpha-toxin. Toxins, 7(12), 5268-5275.
- PHILIPSON, K. D., FRANK, J. S. &NISHIMOTO, A. Y., 1983. Effects of phospholipase C on the Na+-Ca2+ exchange and Ca2+ permeability of cardiac sarcolemmal vesicles. Journal of Biological Chemistry, 258(9), 5905-5910.
- POPOFF, M. R., 2014. Clostridial pore-forming toxins: powerful virulence factors. Anaerobe, 30, 220-238.
- POPOFF, M. R. &BOUVET, P., 2009. Clostridial toxins. Future Microbiology, 4(8), 1021-1064.
- RIGBY, G. J., 1981. An egg-yolk agar diffusion assay for monitoring phospholipase C in cultures of Clostridium welchii. Journal of Applied Bacteriology, 50, 11-19.
- ROBERTSON, S. L., SMEDLEY III, J. G., SINGH, U., CHAKRABARTI, G., VAN ITALLIE, C. M., ANDERSON, J. M. &MCCLANE, B. A., 2007. Compositional and stoichiometric analysis of Clostridium perfringens enterotoxin complexes in Caco‐2 cells and claudin 4 fibroblast transfectants. Cellular Microbiology, 9(11), 2734-2755.
- ROOD, J. I., ADAMS, V., LACEY, J., LYRAS, D., MCCLANE, B. A., MELVILLE, S. B., MOORE, R. J., POPOFF, M. R., SARKER, M. R., SONGER, J. G. &UZAL, F. A., 2018. Expansion of the Clostridium perfringens toxin-based typing scheme. Anaerobe, 53, 5-10.
- ROSSJOHN, J., FEIL, S. C., MCKINSTRY, W. J., TWETEN, R. K. &PARKER, M. W., 1997. Structure of a cholesterol-binding, thiol-activated cytolysin and a model of its membrane form. Cell, 89(5), 685-692.
- RUMAH, K. R., MA, Y., LINDEN, J. R., OO, M. L., ANRATHER, J., SCHAEREN-WIEMERS, N., ALONSO, M. A., FISCHETTI, V. A., MCCLAIN, M. S. &VARTANIAN, T., 2015. The myelin and lymphocyte protein MAL is required for binding and activity of Clostridium perfringens ε-toxin. PLoS Pathogens, 11(5), e1004896.
- SACKS, L. E. &THOMPSON, P. A., 1978. Clear defined medium for the sporulation of C. perfringens. Applied and Environmental Microbiology, 35, 405-410.
- SAKURAI, J. &DUNCAN, D. L., 1977. Purification of beta toxin from Clostridium perfringens type C. Infection and Immunity, 18, 741-745.
- SAKURAI, J. &NAGAHAMA, M., 1985a. Tryptophan content of Clostridium perfringens epsilon toxin. Infection and Immunity, 47, 260-263.
- SAKURAI, J. &NAGAHAMA, M., 1985b. Role of one tryptophan residue in the lethal activity of Clostridium perfringens epsilon toxin. Biochemical and Biophysical Research Communications, 28, 760-766.
- SAKURAI, J. &NAGAHAMA , M., 1986. Amino groups in Clostridium perfringens epsilon prototoxin and toxin. Microbial Pathogenesis, 1, 417-423.
- SAKURAI, J. &NAGAHAMA, M., 1987. Carboxyl groups in Clostridium perfringens epsilon toxin. Microbial Pathogenesis, 3, 469-474.
- SAKURAI, J. &NAGAHAMA , M., 1987. Histidine residues in Clostridium perfringens epsilon toxin. FEMS Microbiology Letters, 41, 317-319.
- SAKURAI, J. &NAGAHAMA, M., 1987. The inactivation of Clostridium perfringens epsilon toxin by treatment with tetranitromethane and N-acetylimidazole. Toxicon, 25, 279-284.
- SAKURAI, J., NAGAHAMA, M., ODA, M., TSUGE, H. &KOBAYASHI, K., 2009. Clostridium perfringens iota-toxin: structure and function. Toxins, 1(2), 208-228.
- SAKURAI, J., NAGAHAMA, M. A. S. A. H. I. R. O. &FUJII, Y. O. S. H. I. O., 1983. Effect of Clostridium perfringens epsilon toxin on the cardiovascular system of rats. Infection and Immunity, 42(3), 1183-1186.
- SAKURAI, M. N. T. U. C. &NAKAJIMA, H., 1989. Nucleotide sequence of capsid protein gene of porcine parvovirus. Virus Research, 13, 79–86.
- SATO, H., YAMAKAWA, Y., ITO, A. &MURATA, R., 1978. Effect of zinc and calcium ions on the production of alpha-toxin and proteases by Clostridium perfringens. Infection and Immunity, 20(2), 325-333.
- SAVVA, C. G., CLARK, A. R., NAYLOR, C. E., POPOFF, M. R., MOSS, D. S., BASAK, A. K., TITBALL, R. W. &BOKORI-BROWN, M., 2019. The pore structure of Clostridium perfringens epsilon toxin. Nature Communications, 10(1), 1-10.
- SAYEED, S., LI, J. &MCCLANE, B. A., 2007. Virulence plasmid diversity in Clostridium perfringens type D isolates. Infection and Immunity, 75(5), 2391-2398.
- SAYEED, S., LI, J. &MCCLANE, B. A., 2010. Characterization of virulence plasmid diversity among Clostridium perfringens type B isolates. Infection and Immunity, 78(1), 495-504.
- SAYEED, S., UZAL, F. A., FISHER, D. J., SAPUTO, J., VIDAL, J. E., CHEN, Y., GUPTA, P., ROOD, J. I. &MCCLANE, B. A., 2008. Beta toxin is essential for the intestinal virulence of Clostridium perfringens type C disease isolate CN3685 in a rabbit ileal loop model. Molecular Microbiology, 67(1), 15-30.
- SCHMIDT, G., PAPATHEODOROU, P. &AKTORIES, K., 2015. Novel receptors for bacterial protein toxins. Current Opinion in Microbiology, 23, 55-61.
- SEIKE, S., TAKEHARA, M., KOBAYASHI, K. &NAGAHAMA, M., 2019. Clostridium perfringens Delta-Toxin Damages the Mouse Small Intestine. Toxins, 11(4), 232.
- SHAHIDI, S. A. &FERGUSON, A. R., 1971. New quantitative, qualitative and confirmatory media for rapid analysis of food for Clostridium perfringens. Applied Microbiology, 21, 500-506.
- SHRESTHA, A. &MCCLANE, B. A., 2013. Human claudin-8 and -14 are receptors capable of conveying the cytotoxic effects of Clostridium perfringens enterotoxin. mBio, 4, e00594-12.
- SHRESTHA, A., UZAL, F. A. &MCCLANE, B. A., 2016. The interaction of Clostridium perfringens enterotoxin with receptor claudins. Anaerobe, 41, 8-26.
- SMART, J. L., ROBERTS, T. A., STRINGER, M. F. &SHAH, N., 1979. The incidence and serotypes of Clostridium perfringens on beef, pork and lamb carcasses. Journal of Applied Bacteriology, 46(2), 377-383.
- SMITH, L. D. S., 1979. Virulence factors of Clostridium perfringens. Reviews of Infectious Diseases, 1, 254–262.
- SMITH, L. D. S. &GARDNER, V. M., 1949. Vegetative cells of Clostridium perfringens in soil. Journal of Bacteriology, 58, 407-408.
- SMITH, L. D. S. &WILLIAMS, B. L., 1984. The Pathogenic Anaerobic Bacteria. 3rd edition, Springfield, Illinois: Charles C. Thomas.
- SMYTH, C. J. &ARBUTHNOTT, J. P., 1974. Properties of Clostridium perfringens (welchii) type A alpha toxin (phospholipase C) purified by electrofocusing. Journal of Medical Microbiology, 7, 41-66.
- SMYTH, C. J. &DUNCAN, C. L., 1978. In: JELJASZEWICZ, J. & WADSTRÖM, T., (eds.). Bacterial Toxins and Cell Membranes. New York: Academic Press.
- SONGER, J. G. &MEER, R. R., 1996. Genotyping of Clostridium perfringens by polymerase chain reaction is a useful adjunct to diagnosis of clostridial enteric disease in animals. Anaerobe, 2, 197-203.
- STEPHEN, J. &PIETROWSKI, R. A., 1986. Bacterial Toxins. 2nd edition. England: Van Nostrand Reinhold.
- STEVENS, D. L., MITTEN, J. &HENRY, C., 1987. Effects of α and θ toxins from Clostridium perfringens on human polymorphonuclear leukocytes. Journal of Infectious Diseases, 156(2), 324-333.
- STEVENS, D. L., TROYER, B. E., MERRICK, D. T., MITTEN, J. E. &OLSON, R. D., 1988. Lethal effects and cardiovascular effects of purified α-and θ-toxins from Clostridium perfringens. Journal of Infectious Diseases, 157(2), 272-279.
- SUNAGAWA, H., TSUZUKI, T., TAKESHI, K., ANDO, Y. &OKA, S., 1987. Enterotoxigenicity of heat-resistant and heat-sensitive strains of Clostridium perfringens. Japanese Journal of Veterinary Science, 49(5), 853-858.
- THEORET, J. R., UZAL, F. A. &MCCLANE, B. A., 2015. Identification and characterization of Clostridium perfringens beta toxin variants with differing trypsin sensitivity and in vitro cytotoxicity activity. Infection and Immunity, 83(4), 1477-1486.
- TITBALL, R. W., NAYLOR, C. E. &BASAK, A. K., 1999. The Clostridium perfringens α-toxin. Anaerobe, 5(2), 51-64.
- TSUGE, H., NAGAHAMA, M., ODA, M., IWAMOTO, S., UTSUNOMIYA, H., MARQUEZ, V. E., KATUNUMA, N., NISHIZAWA, M. &SAKURAI, J., 2008. Structural basis of actin recognition and arginine ADP-ribosylation by Clostridium perfringens ι-toxin. Proceedings of the National Academy of Sciences, 105(21), 7399-7404.
- TWETEN, R. K., 1988. Nucleotide sequence of the gene for perfringolysin O from Clostridium perfringens: significant homology with the genes for streptolysin and pneumolysin. Infection and Immunity, 56, 3235-3240.
- UZAL, F. A., FREEDMAN, J. C., SHRESTHA, A., THEORET, J. R., GARCIA, J., AWAD, M. M., ADAMS, V., MOORE, R. J., ROOD, J. I. &MCCLANE, B. A., 2014. Towards an understanding of the role of Clostridium perfringens toxins in human and animal disease. Future Microbiology, 9(3), 361-377.
- UZAL, F. A., MCCLANE, B. A., CHEUNG, J. K., THEORET, J., GARCIA, J. P., MOORE, R. J. &ROOD, J. I., 2015. Animal models to study the pathogenesis of human and animal Clostridium perfringens infections. Veterinary Microbiology, 179(1-2), 23-33.
- UZAL, F. A., NAVARRO, M. A., LI, J., FREEDMAN, J. C., SHRESTHA, A. &MCCLANE, B. A., 2018. Comparative pathogenesis of enteric clostridial infections in humans and animals. Anaerobe, 53, 11-20.
- UZAL, F. A., SAPUTO, J., SAYEED, S., VIDAL, J. E., FISHER, D. J., POON, R., ADAMS, V., FERNANDEZ-MIYAKAWA, M. E., ROOD, J. I. &MCCLANE, B. A., 2009. Development and application of new mouse models to study the pathogenesis of Clostridium perfringens type C enterotoxemias. Infection and Immunity, 77(12), 5291-5299.
- UZAL, F. A., VIDAL, J. E., MCCLANE, B. A. &GURJAR, A. A., 2010. Clostridium perfringens toxins involved in mammalian veterinary diseases. Open Toxinology Journal, 2, 24.
- VANCE, H. N., 1967. A survey of the alimentary tract of cattle for Clostridium perfringens. Canadian Journal of Comparative Medicine in Veterinary Science, 3, 260-267.
- WILLIS, A. T., 1977. Anaerobic Bacteriology: Clinical and Laboratory Practice. London, Boston: Butterworths.
- WORTHINGTON, R. W., MULDERS, M. S. &VAN RENSBURG, J. J., 1973. Enzymatic activation of Clostridium perfringens epsilon prototoxin and some biological properties of activated toxin. Onderstepoort Journal of Veterinary Research, 40, 153-156.
- YAN, X. X., PORTER, C. J., HARDY, S. P., STEER, D., SMITH, A. I., QUINSEY, N. S., HUGHES, V., CHEUNG, J. K., KEYBURN, A. L., KALDHUSDAL, M. &MOORE, R. J., 2013. Structural and functional analysis of the pore-forming toxin NetB from Clostridium perfringens. MBio, 4(1), e00019-13.